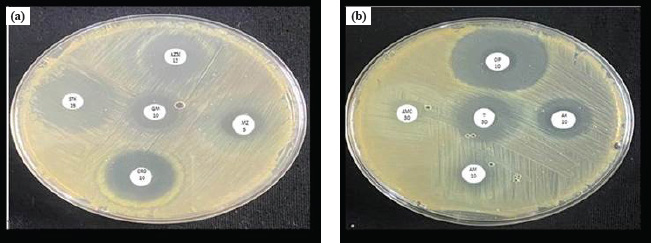

| Research Article | ||
Open Vet. J.. 2025; 15(7): 3317-3324 Open Veterinary Journal, (2025), Vol. 15(7): 3317-3324 Research Article Microscopic vision of mouse kidney experimentally infected with Escherichia coli O157:H7 to determine the therapeutic effect by Trimethoprim-Sulfamethoxazole compared to CiprofloxacinKhulood Naji Rasheed1 , Ateen Amer Hameed2* and Hala Mohammed Majeed31Anatomy and Histology Department, College of Medicine, Tikrit University, Tikrit, Iraq 2Biology Department, College of Science, Tikrit University, Tikrit, Iraq 3Basic Sciences Department, College of Medicine, Ibn Sina University for Medical and Pharmaceutical Sciences, Baghdad, Iraq *Corresponding Author: Ateen Amer Hameed. Biology Department, College of Science, Tikrit University, Tikrit, Iraq. Email: ateen.hamid23 [at] tu.edu.iq Submitted: 13/02/2025 Revised: 09/06/2025 Accepted: 28/06/2025 Published: 31/07/2025 © 2025 Open Veterinary Journal
ABSTRACTBackground: Enterohemorrhagic E. coli (EHEC) is known to be the main cause of bloody diarrhea and hemolytic uremic syndrome; therefore, it is the main cause of acute renal failure resulting from food contamination, or undercooked food. EHEC is one of the most common disease-producing strains in developing countries. The majority of cases of hemorrhagic intestinal diarrhea in humans are caused by the O157:H7 serotype. Aim: This study aimed to understand the pathophysiology of E. coli O157: H7 and how an experimental infection with this bacterium affects the histological structure of the kidneys in male mice, as well as to determine the therapeutic effect of an approved drug (Trimethoprim-Sulfamethoxazole) in the treatment of bacteria and compare it with an antibiotic (Ciprofloxacin) whose effectiveness is tested in vitro. Methods: Identification of the bacteria being studied and their classification is verified by isolating the bacteria using culture media and biochemical diagnosis using the Vitek device. An antibiotic sensitivity test was carried out for 10 antibiotics, calculation and determination of the bacterial count infectious dose, and the half-lethal dose (LD-50) were carried out by using the Reed–Muench method. Glass slides of kidney tissue were prepared using the sectioning method. Results: Bacteria were sensitive to most antibiotics used except Amoxicillin/clavulanic acid and ampicillin, to which they showed resistance. Ciprofloxacin exhibited the highest level of sensitivity among the antibiotics tested, with Trimethoprim-Sulfamethoxazole placed second. Animals that have been intentionally infected with these bacteria exhibit various levels of clinical symptoms, while histological examination revealed acute atrophy in several renal glomeruli, fragmentation in others, and dilatation of the capsular or urinary space, narrowing in some urinary tubules cavities, disintegration of the epithelium, inflammatory cellular infiltration, congestion, and hemorrhage in comparison to the other groups. Conclusion: Trimethoprim-Sulfamethoxazole and Ciprofloxacin were active in stopping diarrhea, and, regaining some activity in the mice, but tissue lesions were still evident in the mice group treated with Trimethoprim-Sulfamethoxazole and the other group treated with the antibiotic Ciprofloxacin. The LD-50 dose group exhibited more severe levels of these symptoms. Regarding the groups that received the two antibiotics, their ability to stop diarrhea was observed, although the mice still experienced various types of tissue damage. Keywords: E. coli O157: H7 pathogenesis, Kidney, Antibiotic, Drug, Histological effect of E. coli O157: H7. IntroductionEscherichia coli is the most important and common bacteria among the Enterobacteriaceae, and its natural location is the digestive tract of humans and animals, as some strains of this bacteria can cause infections of the digestive and urinary tracts (Bai et al., 2022), and its presence in the digestive tract naturally is beneficial to the host, due to its production of vitamin K and its competition with other pathogens that enter the intestinal tract, but if the appropriate conditions are available, it becomes an opportunistic pathogen that causes various infections, including urinary tract infections Uropathogenic E. coli (Biswas et al., 2024). Enterohemorrhagic E. coli (EHEC) is known to be the main cause of bloody diarrhea and hemolytic uremic syndrome; therefore, it is the main cause of acute renal failure resulting from food contamination or undercooked food. EHEC is one of the most common disease-producing strains in developing countries. The majority of cases of hemorrhagic intestinal diarrhea in humans are caused by the O157:H7 serotype, a pathogen that is commonly transmitted between individuals and animals through nourishment (Rani et al., 2021). The exact mechanism by which this bacterium causes disease is not fully understood. Nevertheless, disease development is significantly influenced by the presence of specific virulence factors. The production of Shiga toxins is a critical virulence factor. Shiga Toxin E. coli (STEC) is the bacteria responsible for the production of these toxins. When varying amounts of these toxins enter the bloodstream, they damage blood vessels in specific organs, particularly the kidneys. Both free Shiga toxin and the toxin associated with neutrophils contribute to the inflammation of glomerular endothelial cells and urinary tubules. Additionally, cytokines activate the coagulation system, leading to fibrin accumulation. This process ultimately leads to the development of hemolytic anemia, thrombocytopenia, and acute renal failure (Greig et al., 2023). Additional factors contributing to their virulence include their ability to survive in acidic conditions, the secretion of the enzyme hemolysin, the possession of fimbriae for adherence to urinary system epithelial cells, and the possession of flagella for adherence to intestinal lining cells. Furthermore, they are capable of forming lesions on intestinal villi, leading to reduced absorption capacity of the intestinal mucosa, disruption of ionic balance, and subsequent occurrence of diarrhea (Heydari et al., 2020). Because the kidneys are among the organs most vulnerable to damage from blood toxins, due to the constant filtration of large volumes of blood, it is an excellent model for studying the toxic and tissue effects of E. coli O157:H7, and for understanding the pathological mechanisms that cause kidney failure in severe cases. Materials and MethodsChemicals and culture agarsThe conventional MacConkey agar is employed for the purpose of isolating bacteria, Sorbitol MacConkey (SMAC) agar is utilized to definitively diagnose it, and Hichrom agar is considered a selective medium for E. coli O157:H7, as well as (EMB) agar. Kidney tissue sections were prepared using traditional tissue preparation criteria. Bacterium isolatesThe E. coli O157:H7 isolate that was previously diagnosed and prepared for use was employed. However, certain cultural laboratory tests are carried out to confirm the diagnosis’ correctness. Using biochemical tests. The modified Bauer-Kirby technique is which was approved by the World Health Organization, is used for antibiotic susceptibility testing (Bauer et al., 1966). Calculation and determination of the bacterial count, infectious dose, and half-lethal dose (LD-50)The Reed and Muench (1938) method was used to calculate the LD-50 and infectious doses, whereas the Pour plate method was used to determine the bacterial count (Rasheed et al., 2024). Experimental designA total of 48 male mice of the Balb/c strain, aged between 8 and 12 weeks and weighing between 22 and 28 g, were randomly assigned to six groups. Each group consisted of eight animals. Using only males reduces individual variations resulting from differences in hormone levels among females, making the results more consistent and easier to interpret statistically, as males are easier to raise and monitor. These groups are as follows:- 1-The control group: received 1 milliliter of a physiological solution daily. 2-A second group: treated with a lethal dosage (LD-50) of E. coli O157:H7 at an amount of 9 × 102 cells per milliliter. 3-The third group: treated with an infectious dosage of bacteria at a concentration of 5 × 105 cells per milliliter. 4-The fourth group was administered the antibiotic Trimethoprim-Sulfamethoxazole at a dosage of 1 ml per day, with an amount of 102.88 mg/kg, according to (Nair and Jacob, 2016). 5-Finally, the fifth group was administered Ciprofloxacin, an antibiotic, at a dosage of 102.88 mg/kg, using the method described by (Nair and Jacob, 2016). 6-The sixth group: received antibacterial agents, Trimethoprim-Sulfamethoxazole and Ciprofloxacin, at a dosage of 102.88 mg/kg for each drug. Glass slides of kidney tissue were prepared using the sectioning method. This procedure involves a series of steps: Fixation, washing, dehydration, clearing, infiltration, embedding, trimming, sectioning, staining, and mounting (Luna, 1968). Then, the tissue sections were examined and photographed under a light microscope at different magnification powers. Ethical approvalThis study involved the use of laboratory animals, which were humanely euthanized in accordance with institutional and international ethical guidelines for the care and use of laboratory animals. All experimental procedures were reviewed and approved by the Research Ethics Committee of the College of Medicine, Tikrit University. The study was conducted in full compliance with the ethical standards and regulations established for the humane treatment of animals in scientific research. ResultsIdentification and diagnosis of E. coli O157:H7The identification of the bacteria being studied and their classification is verified by isolation of the bacteria using culture media, and biochemical diagnosis using the Vitek device. As in Figure 1a–d. Evaluating the susceptibility of E. coli O157:H7 to antibioticsThe bacteria were found to be sensitive to the antibiotics, Trimethoprim-Sulfamethoxazole, Metronidazole, Gentamicin, Amikacin, Azithromycin Ceftriaxone, Tetracycline, and Ciprofloxacin. While resistant to Ampicillin and Amoxicillin/clavulanic acid. Among the antibiotics examined, ciprofloxacin had the greatest degree of sensitivity, followed by trimethoprim-sulfamethoxazole as shown in Figure 2a and b. Histopathological examinationHistological examination of the mice of the first group showed a clear distinction between the cortex and the medulla through the presence of renal corpuscles (Bowman’s capsule and glomerulus) in the cortex and their absence in the medulla, as in Figure 3a, and that the kidneys mass is occupied by proximal convoluted tubules and distal convoluted tubules as well as blood vessels, as in Figure 3b. The results of the second group showed pathological changes as illustrated by the occurrence of acute atrophy in a number of renal glomeruli and fragmentation of other glomeruli with dilatation of the capsular/urinary space around them, as well as degeneration of the epithelium lining the parietal layer of Bowman’s capsule and the appearance of the latter devoid of a glomerulus in one of the tissue sections, degeneration of the epithelium lining a number of urinary tubules and hyperplasia in the lining of other urinary tubules were also observed, which led to the closure of their cavities, furthermore the spread of hemorrhage and inflammatory cells infiltration around the urinary tubules and on the surface of the glomeruli and around the blood vessels, as in Figure 4a–c. While the histological examination of the third group showed acute atrophy of the glomerulus, dilatation of the capsular space around it, as well as complete fragmentation of other glomeruli, acute degeneration of the epithelium lining some urinary tubules and necrosis appeared in others, and congestion of a number of blood vessels with a rupture in the wall of one of them, as well as hemorrhage in the interstitial tissue, and inflammatory exudate and hemosiderin deposition with cellular infiltration were observed, as in Figure 5a–c. The histological section of the fourth group were represented by atrophy and fragmentation of the glomeruli, dilatation of the capsular space around them, degeneration and necrosis of the epithelium lining the urinary tubules, as well as hyperplasia of its cells and closure of its cavities, with the remains of traces of hemorrhage and the appearance of inflammatory cells, as in Figure 6a–c.
Fig. 1. (a) E. coli on EMB agar (b) E. coli on MacConkey agar (c) E. coli O157:H on SMAC agar (d) E. coli O157:H7 on Hichrom agar.
Fig. 2. (a) Bacteria sensitivity to Amikacin, Tetracycline and Ciprofloxacin and their resistance to Ampicillin and Amoxicillin/clavulanic acid (b) Antibiotic sensitivity in bacteria. Trimethoprim-Sulfamethoxazole, Metronidazole, Gentamicin, Azithromycin, and Ceftriaxone.
Fig. 3. (a) Micrograph of a cross-section of a mouse kidney (cortex) from the first group, showing the normal appearance of the renal glomerulus (A), Bowman’s space (B), and Bowman’s capsule (C) (H&E, ×40) (b) Micrograph of a cross-section of a mouse kidney (medulla region) from the first group, showing normal appearance of urinary tubules (A), and loops of Henle̕s (B) (H&E, ×40).
Fig. 4. (a) Micrograph of a cross-section of a mouse kidney from the second group, showing hemorrhage (A) with acute inflammatory cell infiltration around the urinary tubules (B) (H&E, ×40) (b) Micrograph of a cross-section of a mouse kidney from the second group, showing acute atrophy in one of the two glomeruli (A) and fragmentation in the other glomerulus (B), dilatation of the capsular/urinary space in both (C), as well as inflammatory cell infiltration on their surfaces (D), degeneration of the epithelium lining the parietal layer of Bowman’s capsule (E), degeneration of the lining epithelium in a number of urinary tubules (F) and desquamation into the lumen of other tubules (G) (H&E, ×40) (c) Micrograph of a cross-section of a mouse kidney from the second group, showing complete glomerular fragmentation (A) with dilatation of the capsule/urinary space (B) around it, as well as the appearance of a Bowman’s capsule devoid of a glomerulus (C), degeneration of the epithelium lining a number of urinary tubules (D) hyperplasia in the lining of other urinary tubules leading to closure of their cavities (E), inflammatory cell infiltration (F) around an arterial blood vessel (G) (H&E, ×40). The results of the fifth group also indicated the appearance of complete fragmentation of a number of glomeruli, and partial fragmentation of a number of others, with acute degeneration of the epithelium lining some urinary tubules and necrosis in others, and glass molds (homogeneous crystalline protein material) appeared in the cavities of a number of urinary tubules, and focal accumulation of inflammatory cells, as well as the occurrence of hemorrhage in the interstitial tissue, as in Figure 7a and b. In the sixth group, the results showed some pathological changes in the kidney tissue of this group of mice, represented by glomerular fragmentation and hemorrhage on the surface of the glomerulus, necrosis of the lining of several urinary tubules, and widespread hemorrhage throughout the interstitial tissue, as in Figure 8a and b.
Fig. 5. (a) Micrograph of a cross-section of a mouse kidney from the third group, in which acute inflammatory cell infiltration is observed around the urinary tubules throughout the tissue section (H&E, ×40) (b). Micrograph of a cross-section of a mouse kidney from the third group, showing complete glomerular fragmentation (A) with dilatation of the capsular/urinary space (B), hyperplasia of the epithelium lining the urinary tubules throughout the tissue section (C), and infiltration of inflammatory cells (D) (H&E, ×40) (c) Micrograph of a cross-section of a mouse kidney from the third group, showing acute atrophy in one of the two glomeruli (A) and dilatation of the capsular/urinary space around it (B), degeneration of the epithelium lining some of the urinary tubules (C) and necrosis in other tubules (D), and hemorrhage in the interstitial tissue (E) (H&E, ×40).
Fig. 6. (a) Micrograph of a cross-section of a mouse kidney from the fourth group, showing hemorrhage in the interstitial tissue (A), infiltration of inflammatory cells (B), and degeneration of the epithelium lining several urinary tubules (C) (H&E, ×40) (b) Micrograph of a cross-section of a kidney from the fourth group, showing atrophy of one of the glomeruli (A) and fragmentation of two of them (B), dilatation of the capsular/urinary space (C), acute degeneration of the epithelium lining several urinary tubules (D), necrosis of other tubules (E), and hyperplasia of other tubules leading to closure of their cavities (F) (H&E, ×40) (c) Micrographic of a cross-section of a mouse kidney from the fourth group, showing the rupture of two glomeruli (A), hemorrhage on the surfaces of three glomeruli (B), rupture of the interstitial tissue (C) with hemorrhage in it (D), and necrosis of the epithelium lining several urinary tubules (E) (H&E, ×40).
Fig. 7. (a) Micrograph of a cross-section of a mouse kidney from the fifth group, showing widespread hemorrhage in the interstitial tissue (A), acute degeneration of the epithelium lining the urinary tubules throughout the tissue section (H&E, ×40) (b) Micrograph of a cross-section of a mouse kidney from the fifth group, showing complete fragmentation in one glomerulus (A) and partial fragmentation in another (B), degeneration of the lining of several urinary tubules (C) and necrosis in others (D), and hemorrhage in the interstitial tissue (E) (H&E, ×40).
Fig. 8. (a) Micrograph of a cross-section of a mouse kidney from the sixth group, in which hemorrhage is observed in the interstitial tissue throughout the tissue section (H&E, ×40) (b) Micrograph of a cross-section of a mouse kidney from the sixth group, showing fragmentation of one of the two glomeruli (A) with hemorrhage on their surfaces (B), as well as hemorrhage in the interstitial tissue (C), and necrosis of the lining of several urinary tubules (D) (H&E, ×40). DiscussionOur results agree with Al-Taie (2020) in his study of isolating and diagnosing E. coli O157:H7. They appear as pink colonies on MacConkey agar because they ferment lactose sugar, and are characterized by the phenomenon of metallic luster on EMB agar. Our results also agree with Yadav et al. (2018) and Hameed et al. (2022) in the appearance of typical colonies of these bacteria that are colorless because they do not ferment the sorbitol sugar on SMAC agar, while the pink-purple colonies indicate E. coli O157:H7. In a study performed by Klaif et al. (2019) and Hameed et al. (2023), they found that Hichrom agar of E. coli bacteria of the O157:H7 serotype is useful for the diagnosis of this bacteria, as our findings are consistent with Tawfiq (2006) investigation of coliform bacteria isolated from hospitals in KSA. Tawfiq’s research revealed a significant level of resistance to ampicillin, and Ali (2012) confirmed these findings, except for his observations on the bacteria’s resistance to Trimethoprim and Amoxicillin/clavulanic acid. Our findings did not agree with his study nor with Nguyen and others (2005) study, which reached similar conclusions. Our results align with the researcher Mahdi (2019) findings about the susceptibility of E. coli to Ciprofloxacin and Trimethoprim. Many studies have shown that the presence of bacteria outside the intestines is a cause of other diseases, the most important of which is urinary tract infection, which leads to kidney inflammation and damage to the reproductive tract, the intestinal infection may develop to reach the urinary tract through the bloodstream to the kidney, which is called renal dysfunction, which is one of the dangerous diseases of the urinary system (Saidu and Ebiala, 2022). E. coli also causes acute pyelonephritis, in which the affected kidney is small in size. As a result of kidney inflammation, especially the glomeruli, there is a severe deterioration in kidney function and a decrease in the glomerular filtration rate, which leads to what is called renal failure, which is often accompanied by an increase in creatinine, potassium, and phosphate (Alconcher et al., 2021). The results of this research are consistent with the results of previous studies. Kerns et al. (2023) stated that tissue toxicity appears in tissue sections in the form of cell degeneration accompanied by the formation of vacuoles and tissue necrosis. Wang et al. (2020) attributed the pathological tissue changes in the kidney to a decrease/increase in the filtration rate, especially in bacterial and viral infections. Casuscelli et al. (2023) mentioned that glomerulolysis is attributed to the degeneration of mesangial cells that support the walls of the glomerulus capillaries (through the cellular response to vascular active substances in order to maintain a constant hydrostatic pressure to achieve an ideal filtration rate). Sun et al. (2020) also found that mesangial cell degeneration affects kidney function, as these cells contribute as well as supporting the capillary walls to removing filtration deposits from the glomerular basement membrane, and phagocytosing foreign materials. Obrișcă et al. (2022) reported acute congestion in the interstitial tissue and signs of internal hemorrhage, as well as lymphocytic infiltration around the renal corpuscles and between the urinary tubules, which is indicative of nephritis. The damaged glomeruli, renal tubules, and blood vessels secrete chemical mediators that attract inflammatory cells to help in the inflammatory infiltration. Elbaset et al. (2020) attributed the occurrence of acute hemorrhage and congestion in affected kidney tissue to direct damage (degeneration and necrosis) of epithelial cells lining blood vessels. Buelli et al. (2022) attributed the renal histopathological changes associated with bacterial infection to the production of verotoxin by E. coli, which is a strong oxidizing agent that increases the number of mesangial cells and the urinary space. These toxins increase oxidation processes within cells, leading to the release of free radicals, which in turn react with the lipids of cell membranes, causing their oxidation, which in turn leads to damage to the functions of these membranes. Bacterial toxins also reduce antioxidants in cells, such as glutathione, which works to inhibit peroxidation processes and free radicals that have a harmful effect on tissues. In cases of acute bacterial infection, diarrhea is observed to be followed by the pathological symptoms of hematuria, which is a dangerous urinary tract disease, characterized by kidney dysfunction with the presence of urea in the blood (Liu et al., 2022). ConclusionHichrom agar for E. coli O157:H7 is one of the important and accurate culture media in diagnosing these bacteria compared to traditional media, as E. coli O157:H7, producing the Shiga toxin STEC, was able to cause many tissue lesions in the kidneys. Trimethoprim-Sulfamethoxazole and Ciprofloxacin were active in stopping diarrhea and regaining some activity of the mice, but the tissue lesions were still evident in the mice group that treated with Trimethoprim-Sulfamethoxazole and the other group treated with the antibiotic Ciprofloxacin. Noting that these changeslesions were less severe when the mice were treated with the two antibiotics together than when the mice were treated with the two antibiotics separately. AcknowledgmentsFirst and foremost, I would like to express my sincere gratitude to everyone who contributed to the completion of this work, whether by providing advice or assistance. I am also thankful to [Tikrit University/Biology department] for providing the resources and environment necessary to complete this work. Special thanks to my family and friends for their encouragement, patience, and unwavering support during this journey. Conflict of interestThere is no conflict of interest regarding the publication of this paper. FundingThis research received no external funding. Authors’ contributionsAuthor 1 conceived and designed the study, conducted the main analysis, drafted the manuscript, provided academic supervision, and final approval of the manuscript. Author 2 contributed to data collection, interpretation of the results, and critical revision of the manuscript. Author 3 assisted in the methodology design and provided academic supervision. All authors read and approved the final version of the manuscript. Data availabilityThe data that support the findings of this study are available from the corresponding author upon reasonable request. ReferencesAlconcher, L.F, Balestracci, A., Coccia, P.A., Suarez, A.D.C., Ramírez, F.B., Monteverde, M.L. and Rivas, M. 2021. Hemolytic uremic syndrome associated with Shiga toxin-producing Escherichia coli infection in Argentina: update of serotypes and genotypes and their relationship with severity of the disease. Pediatr. Nephrol. (36), 2811–2817. Ali, S.A. 2012. Study of the effect of Zamzam water and the antibiotic Azithromycin on the morphological changes and histological lesions caused by Escherichia coli bacteria in some organs of white mice. Master’s thesis/ College of Science—Tikrit University. Al-Taie, K.M.A. 2020. Isolation and study of the pathogenicity of the virulent Escherichia coli bacteria in dogs. Master’s thesis/ College of Veterinary Medicine—Tikrit University. Bai, Z., Xu, X., Wang, C., Wang, T., Sun, C., Liu, S. and Li, D. 2022. A comprehensive review of detection methods for Escherichia coli O157: H7. TrAC. 152, 116646. Bauer, A.W., Kirby, W.M., Sherris, J.C. and Turch, M. 1966. Anti- biotic susceptibility testing by standardized disk method. Am. Clin. Pathol. (45), 493–496. Biswas, S., Khuntia, H.K., Bal, M., Pati, S., Dixit, S., Pattanaik, S.S. and Ranjit, M. 2024. Prevalence and antimicrobial resistance patterns of diarrheagenic and uropathogenic Escherichia coli in Odisha, India. OHB 4(2), 85–92. Buelli, S., Locatelli, M., Carminati, C.E., Corna, D., Cerullo, D., Imberti, B. and Morigi, M. 2022. Shiga toxin 2 triggers C3a-dependent glomerular and tubular injury through mitochondrial dysfunction in hemolytic uremic syndrome. Cells 11(11), 1755. Casuscelli, C., Longhitano, E., Maressa, V., Di Carlo, S., Peritore, L., Di Lorenzo, S. and Santoro, D. 2023. Autoimmunity and infection in glomerular disease. Microorganisms 11(9), 2227. Elbaset, M.A., Zahran, M.H., El-Baz, R., Badawy, M. and Osman, Y. 2020. Spontaneous renal hemorrhage: critical analysis of different lines of management in non-traumatic patients: a single tertiary center experience. Int. Urol. Nephrol. (52), 423–429. Greig, D.R., Do Nascimento, V., Olonade, I., Swift, C., Nair, S. and Jenkins, C. 2023. Surveillance of antimicrobial resistant Shiga toxin-producing E. coli O157: H7 in England, J. Antimicrob. Chemother. 78(9), 2263–2273. Hameed, A.A., Rasheed, K.N. and Majeed, H.M. 2022. A histological microscopic view of the white mouse brain dosed experimentally with Escherichia coli O157: H7 and treated with a drug and antibiotic. Ann. For. Res. 65(1), 9935–9946. Hameed, A.A., Rasheed, K.N. and Majeed, H.M. 2023. Histological comparison of white mouse liver dosed experimentally with Escherichia Coli O157: H7 and treated with a drug and antibiotic. Ann Rom Soc Cell Biol. 27(1), 64–75. Heydari, F.E., Bonyadian, M., Moshtaghi, H. and Sami, M. 2020. Prevalence and antibiotic resistance profile of Shiga toxin-producing Escherichia coli isolated from diarrheal samples. IJM. 12(4), 289. Kerns, S.L., Hall, W.A., Marples, B. and West, C.M. 2023. Normal tissue toxicity prediction: clinical translation on the horizon. Semin Radiat Oncol. 3(33), 307–316. Klaif, S.F., Saleh, Z.F., Hussein, M.T., Jawad, A.A. and Jawad, M.S. 2019. Molecular characterization of enterohemorrhagic E. coli O157 and O153 isolated from tissue camel and human stool samples in Al-Diwaniyah, Iraq. Iraqi J. Vet. Sci. 33(1), 81–86. Liu, Y., Thaker, H., Wang, C., Xu, Z. and Dong, M. 2022. Diagnosis and treatment for Shiga toxin-producing Escherichia coli associated hemolytic uremic syndrome. Toxins 15(1), 10. Luna, L. 1968. Manual of histological staining methods of the Armed Forces Institute of Pathology. 3rd ed. New York, NY: The Blakiston Division. McGraw- Hill Book Co. Mahdi, E.M. 2019. Histological comparison of the effect of the antibiotic Ciprofloxacin and the aqueous and alcoholic extracts of Petroselinum crispu (parsley) in several internal organs of white mice experimentally infected with E. coli bacteria. Master’s thesis/ College of Science—Tikrit University. Nair, A.B. and Jacob, S. 2016. A simple practice guide for dose conversion between animals and human. J. Basic Clin. Pharm. (7), 27–31. Nguyen, T.V., Le Van, P., Le Huy, C., Gia, K.N. and Weintraub, A. 2005. Detection and characterization of diarrheagenic Escherichia coli from young children in Hanoi, Vietnam. J. Clin. Microbiol. 43(2), 755–760. Obrișcă, B., Vornicu, A., Procop, A., Herlea, V., Terinte-Balcan, G., Gherghiceanu, M. and Ismail, G. 2022. A histology-guided approach to the management of patients with lupus nephritis: are we there yet? Biomedicines 10(6), 1409. Rasheed, K.N., Ibrahim, Y.W. and Atiyea, Q.M. 2024. Histological and physiological evaluation of Salmonella Spp. pathogenicity experimentally dosed in male Albino Mice. South Asian Res. J. Bio. Appl. Biosci. 6(4), 120–131. Rani, A., Ravindran, V.B., Surapaneni, A., Mantri, N. and Ball, A.S. 2021. Trends in point-of-care diagnosis for Escherichia coli O157: H7 in food and water. Int. J. Food Microbiol. 349, 109233. Reed, L.J. and Muench, H. 1938. A simple method of estimating fifty percent end point. A. J. Hyg. 27(3), 493–497 Saidu, J.Z. and Ebiala, F. 2022. Prevalence of E. coli O157: H7 in the urinary tract of apparently healthy students of a Tertiary Institution in Benin City, Nigeria. NAPAS. 5(1), 67–74. Sun, H., Ding, J.M., Zheng, H.H., Lv, K.J., Hu, Y.F., Luo, Y.H. and Gao, J.L. 2020. The effects of Stx2 on the inflammatory pathway in mouse mesangial cells. Mediators Inflamm. (1), 3560793. Tawfiq, J.A. 2006. Increasing antibiotic resistance among isolates of Escherichia coli recovered from inpatients and outpatients in a Saudi Arabian hospital. Infect. Control Hosp. Epidemiol. 27(7), 748–753. Wang, X., Yang, S., Li, S., Zhao, L., Hao, Y., Qin, J. and Ren, F. 2020. Aberrant gut microbiota alters host metabolome and impacts renal failure in humans and rodents. Gut 69(12), 2131–2142. Yadav, M., Bhatiani, A., Bhagoliwal, A., Kumar, A. and Sujatha, R. 2018. Escherichia coli O157: H7 serotypes isolation from children in stool samples. J. Pure. Appl. Microbiol. 12(1), 55–58. | ||
| How to Cite this Article |
| Pubmed Style Rasheed KN, Hameed AA, Majeed HM. Microscopic vision of mouse kidney experimentally infected with Escherichia coli O157:H7 to determine the therapeutic effect by Trimethoprim-Sulfamethoxazole compared to Ciprofloxacin. Open Vet. J.. 2025; 15(7): 3317-3324. doi:10.5455/OVJ.2025.v15.i7.43 Web Style Rasheed KN, Hameed AA, Majeed HM. Microscopic vision of mouse kidney experimentally infected with Escherichia coli O157:H7 to determine the therapeutic effect by Trimethoprim-Sulfamethoxazole compared to Ciprofloxacin. https://www.openveterinaryjournal.com/?mno=242706 [Access: January 25, 2026]. doi:10.5455/OVJ.2025.v15.i7.43 AMA (American Medical Association) Style Rasheed KN, Hameed AA, Majeed HM. Microscopic vision of mouse kidney experimentally infected with Escherichia coli O157:H7 to determine the therapeutic effect by Trimethoprim-Sulfamethoxazole compared to Ciprofloxacin. Open Vet. J.. 2025; 15(7): 3317-3324. doi:10.5455/OVJ.2025.v15.i7.43 Vancouver/ICMJE Style Rasheed KN, Hameed AA, Majeed HM. Microscopic vision of mouse kidney experimentally infected with Escherichia coli O157:H7 to determine the therapeutic effect by Trimethoprim-Sulfamethoxazole compared to Ciprofloxacin. Open Vet. J.. (2025), [cited January 25, 2026]; 15(7): 3317-3324. doi:10.5455/OVJ.2025.v15.i7.43 Harvard Style Rasheed, K. N., Hameed, . A. A. & Majeed, . H. M. (2025) Microscopic vision of mouse kidney experimentally infected with Escherichia coli O157:H7 to determine the therapeutic effect by Trimethoprim-Sulfamethoxazole compared to Ciprofloxacin. Open Vet. J., 15 (7), 3317-3324. doi:10.5455/OVJ.2025.v15.i7.43 Turabian Style Rasheed, Khulood Naji, Ateen Amer Hameed, and Hala Mohammed Majeed. 2025. Microscopic vision of mouse kidney experimentally infected with Escherichia coli O157:H7 to determine the therapeutic effect by Trimethoprim-Sulfamethoxazole compared to Ciprofloxacin. Open Veterinary Journal, 15 (7), 3317-3324. doi:10.5455/OVJ.2025.v15.i7.43 Chicago Style Rasheed, Khulood Naji, Ateen Amer Hameed, and Hala Mohammed Majeed. "Microscopic vision of mouse kidney experimentally infected with Escherichia coli O157:H7 to determine the therapeutic effect by Trimethoprim-Sulfamethoxazole compared to Ciprofloxacin." Open Veterinary Journal 15 (2025), 3317-3324. doi:10.5455/OVJ.2025.v15.i7.43 MLA (The Modern Language Association) Style Rasheed, Khulood Naji, Ateen Amer Hameed, and Hala Mohammed Majeed. "Microscopic vision of mouse kidney experimentally infected with Escherichia coli O157:H7 to determine the therapeutic effect by Trimethoprim-Sulfamethoxazole compared to Ciprofloxacin." Open Veterinary Journal 15.7 (2025), 3317-3324. Print. doi:10.5455/OVJ.2025.v15.i7.43 APA (American Psychological Association) Style Rasheed, K. N., Hameed, . A. A. & Majeed, . H. M. (2025) Microscopic vision of mouse kidney experimentally infected with Escherichia coli O157:H7 to determine the therapeutic effect by Trimethoprim-Sulfamethoxazole compared to Ciprofloxacin. Open Veterinary Journal, 15 (7), 3317-3324. doi:10.5455/OVJ.2025.v15.i7.43 |